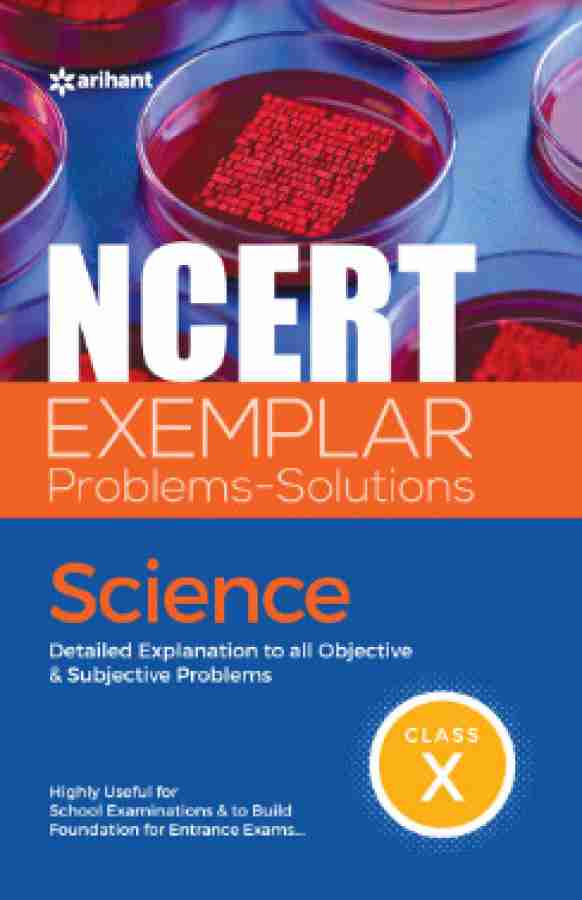

NCERT Exemplar Problems Solutions Science class 10th
NCERT Exemplar Problems Solutions Science class 10th
Couldn't load pickup availability
Book overview
Book Structure:
✍ Covers the entire Science Syllabus in 17 chapters
Book Key Features:
✍ Designed for class X students
✍ Explanatory & Accurate Solutions to all questions given in the NCERT Exemplar Science Book
✍Thinking Process tells how to solve a problem
✍ Notes are provided with special points
✍ Fully Support the practice of NCERT with the right approach
Why this Book?
✍ Latest edition serves as a comprehensive Exercise solution book
✍ Formulated to provide a large number of quality problems
✍ Highly useful for school exams and build the foundation for entrance exams
TABLE OF CONTENT:
Chemical Reactions and Equations, Acids, Bases and Salts, Metals and Non-metals, Carbon and Its compounds, Periodic Classification of Elements, Life Processes, Control, and Coordination, How do Organisms Reproduce?, Heredity and Evolution, Light, Reflection and Refraction, Human Eye and Colourful World, Electricity, Magnetic Effects of Electric Current, Sources of Energy, Our Environment, Management of Natural Resources
Share